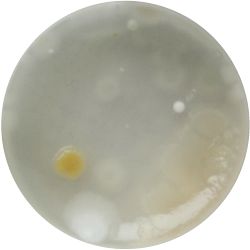
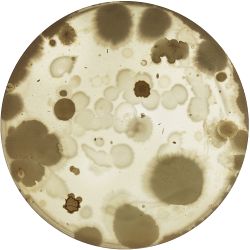
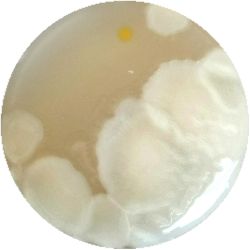
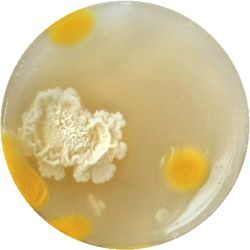
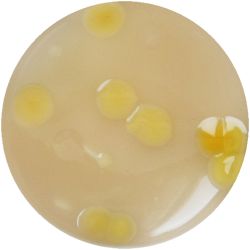
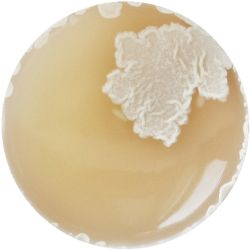
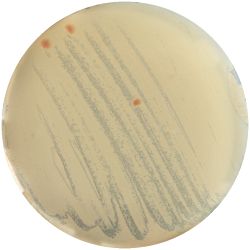
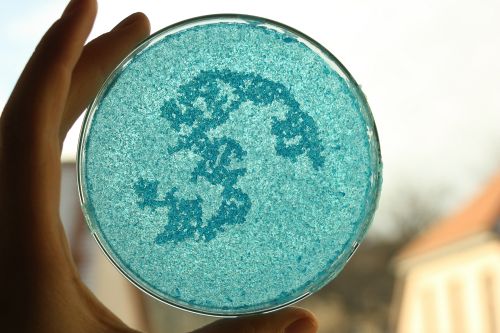

Basic growth medium for bacteria
- How can we, as people without access to a professional laboratory, grow microorganisms?
1. Procedure:
- The petri dishes are cleaned with a solution of 70% Alcohol + 30% of water.
200 ml destilled water/ tapwater 3 ts sugar 2 ts bouillon/ peptone (proteins) 2 g agar (gellant)
We mixed different mediums, varying the ingredients. Tapwater and bouillon are easily accessible, while peptone and destilled water are more specific.
Mine contained distilled water, but instead of peptone I used bullion.
2. Outcome:
- Only the soil sample showed some result. Besides that we can only observe oil drops from the Boullion. Under the microscope I could only identify some sort of funghi, but no bacterial colonies.
Bacteria tasting
- Fermentation is a way of preserving food and the reason for that lies within its sour flavour. Under these sour conditions, neither mushrooms nor bacteria (other than our Lactobacillales) will grow. In our stomachs Lactobacillales takes over important functions and we won't kill it by drinking it. However after taking antibiotics humans can repopulate their gut flora by eating or drinking something probiotic.
1. Milk -> Yoghurt:
kill possibly pathogenic organisms in the milk: 90°C cool milk down to body temperature: 40°C add the Lactobacillales (in a few spoons of yoghurt)
- Inside of the incubator the bacteria eat the lactose found in the milk.
2. Kombucha Tea:
1 cup black/green tea 4 ts (or more) sugar add lent or bought Gluconacetobacter xylinus (after the tea cooled down to room temperature)
Serial dilution
- Under the right conditions one Bacteria can divide itself infinetely and pile up a colony of its kind. The procedure of serial dilution (reducing the amount of bacteria in a solution within steps) is for example useful for counting bacteria. In this way we tried isolating the Gluconacetobacter.
1. Medium for the Gluconacetobacter:
10 g Glucose 2.5 g Peptone 2.5 g Yeast extract 1.35 g Na2HPO4 0.75 g Citric acid 500 ml Distilled water 7.5 g Agar
2. Dilution Procedure
- We had 6 Petridishes that contained our medium and our pipette could collect 3 ml of liquid. As a first step, we blended a piece of the Kombucha skin with 0.5 ml of distilled water and poured a drop onto our first dish. The first 0.5 ml of bacteria-solution was diluted further with additional 2.5 ml of distilled water. Another drop was poured onto the second dish. We emptied the pipette again till we regained the amount of 0.5 ml and added another 2.5 ml of distilled water.
3. Outcome
| 1:1 | 1:6 | 1:36 |

|

|

|
| 1:216 | 1:1296 | 1:7776 |

|

|

|
- We could observe how different bacterial and yeast colonies appeared.
Oil Immersion
- Oil immersion is a method of microscopy, which in our case, increased the resultion another 100 times.
1. Looking at the microscopes lenses
Ocular 10 * magnification Lense 1 0 * (in addition to the Ocular = 10* magnification) Lense 2 10 * (*10 = 100) Lense 3 40 * (*10 = 400) Oil Immersion Lense 100 * (*10 =1000)
- Our sample is placed on a microscope slide and protected by a cover slide. After mounting the slide onto the microscope we added a drop of immersion oil and turned the lense to face our sample. The tip of the lense was then in contact with the drop on our slide.
2. Looking at the Gluconacetobacter xylinus
| 10* magnification | 40* magnification |

|

|
| 100* magnification | 1000* magnification |

|

|
Multiplying Mushrooms
Procedure
- For replicating a mushroom, we need to look for its mycelium (a delicate, white network of branches). In a supermarket we only find the fruiting body seperated from the underground network (mycelium). But on the Oyster mushroom this mycelium can be also found above and under its cap and on its stem.
- So first we try to get grip of some parts (thin slices), using the cutter.
- The mushroom needs moisture and organic material, which it decomposes. For that we use corrugated cardboard and moisten its layers. Alternating we staple a layer of cardboard and a layer of mushroom pieces.
Electric circuit with Soilbacteria
- Anerobic bacteria that live in the soil oxidate substrates during their metabolism for winning energy. During this exothermic reaction, electrons and protons are freed. In our battery, we placed an anode (graphite, copper, zinc, gold) in the mud and a cathode (differing from the metal of the anode) into water
- The mud container is closed, so there is no air that could take away the electrons. Instead, these would be collected by our anode.
- Our protons would search their way through the tube filled with agar that connected the containers, which would act as membrane between those. These then would be caught by our cathode.
Bioluminescence within bacteria
- The bacteria we would like to augment this time can be found in seawater. At a specific deinsity, the enzyme luciferase is created and the bacteria begin to glow.
Seawater Medium
3 g NaCl 0,1 g Glycerol 1 g Peptone 0,3 g Beef Extract 100 ml Distilled Water 1,5 g Agar
Growing Crystals
- Crystals grow when a solution is supersaturated. This happens, when we boil water and add our crystal powder (solute). While the water is hot, it has a higher capacity to dissolve the solute. After cooling the crystals form. We disolved copper sulfate in water.
Gene Isolation and Electrophoresis
Final Project
Skin Variations
- Cellulose is generated as a byproduct of the mircroorganisms that live within Kombucha, a probiotic drink. The aim of this study was to generate skins with different properties by varying the drink or the combination of the organisms.
1. Culture isolation of the most common microorganisms that were found in Kombucha:
1. GLUCONACETOBACTER (bacteria)
/1 l water 20 g D-glucose 5 g yeast extract 5 g peptone 2.7 g disodium phosphate 1.15 g citric acid
| life-size | colony | oil immersion |

|

|
|

|

|
|
|

|
|

|

|
|

|

|

|

|

|

|

|

|
2. CANDIDA ALBICANS (yeast) - Sabouraud agar
/1 l distilled water 20 g D-glucose 5 g yeast extract 5 g peptone 2.7 g disodium phosphate 1.15 g citric acid
| life-size | colony | oil immersion |

|

|

|

|

|
|

|

|

|
3. THERMUS (bacteria)
/1 l distilled water 4 g yeast extract 8 g peptone 2 g NaCl (salt) 30 g agar
| life-size | colony | oil immersion |

|

|
|

|

|
|

|

| |
|

|

|

|

|
4. LEUCOSPORIDIELLA (fungi) -YM agar (yeast malt agar)
/1 l distilled water 3 g yeast extract 3 g malt extract 5 g peptone 10 g dextrose (grape-sugar) 20 g agar
| life-size | colony | oil immersion |

|

|

|
5. LACTOCOCCUS (bacteria)
- (NIZO, the food researchers B.V., Media and growth conditions for Lactococcus lactis)
/1 l water
20 g tryptone (peptone)
5 g yeast extract
4 g sodium chloride (vinegar (maybe))
(I skipped sodium acetate)
0.5 g ascorbic acid (vitamin C)
| life-size | colony | oil immersion |

|

|
|

|

|
|
|

|

|
|

|
|

|

|
6. LACTOBACILLUS (bacteria)- Tomato Juice agar
/1 l water 20 ml tomato juice solids (tomato juice) 10 g peptone 10 g peptonized milk (baby powder) 11 g agar
| life-size | colony | oil immersion |
|

|

|
|

|

|

|

|

|
2. Recombination of Cultures:
- I picked one colony from each medium and spread it on a newly cooked medium.
| Sabouraud Agar | YM Agar | Thermus Medium |

|

|
|
| Lactococcus | Lactobacillus |

|

|
I tried to recombine these bacteria in 16 probes, but after a week, mold spread on the liquid, because the process of fermentation was missing.
3. Kombucha-colony in various drinks:
- I wondered how the choice of drink could affect the material properties of the Kombucha skin. As first reference point I looked at the ingredients of green tea and what else would contain these substances. Futhermore I did some research on where the Gluconabacter lives in nature.
I added 1ml Kombucha to 30 ml of an other drink, that could nourish the microorganisms.
| corn juice | beer | carrot juice |

|

|

|
| superfruit juice | apple juice | coconut juice |

|

|

|